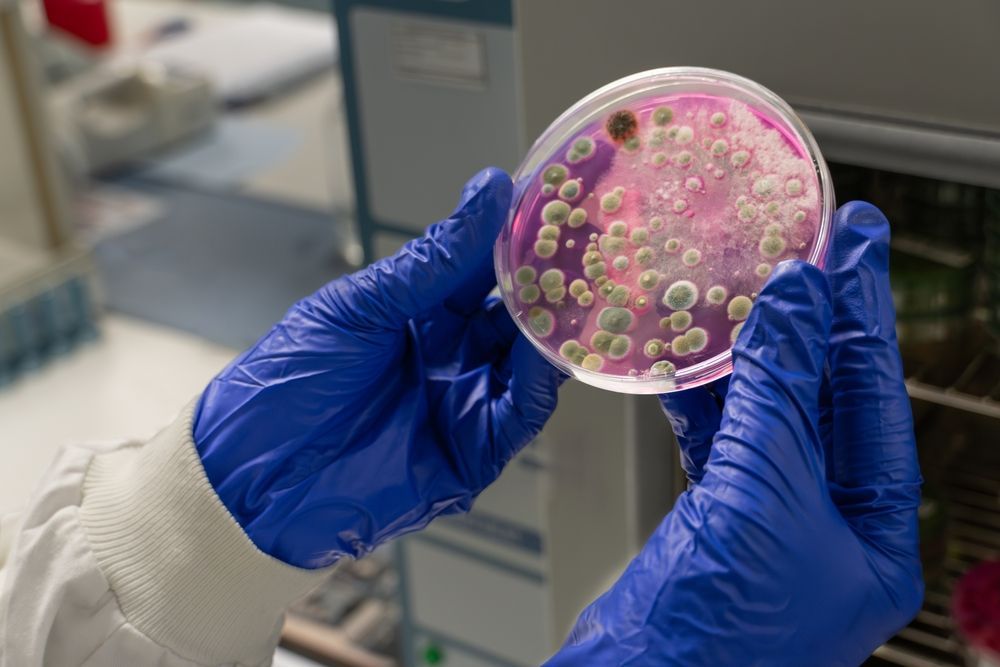

Ensure a Safe Living Environment
Book Mold Inspection Services in Manhattan and The Surrounding Areas
In Manhattan or Junction City, ensuring your home or business is free of mold is crucial for maintaining a safe and healthy environment. At Custom Services and Restoration, we are committed to identifying mold presence and its source. Our mold inspections cover both residential and commercial properties, helping you prevent potential health risks and structural damage. You can expect a quick turnaround time for our services, and we offer free, over-the-phone estimates. Imagine walking into your home, knowing it's mold-free and safe for your family.
Our comprehensive service includes residential and commercial mold inspections, detection of mold presence, and identification of mold sources. We provide free, in-person consultations within 48 hours and guarantee satisfaction. Whether you're dealing with visible mold or suspect hidden growth, our team is ready to assist you in Manhattan.
Schedule your mold inspection today to protect your property.
What’s Included in This Service
Our mold inspection process is thorough and designed to give you peace of mind. We start with a detailed assessment, ensuring every corner of your property is checked. Our team uses advanced techniques to identify mold sources and potential risks:
Residential mold inspections conducted with precision
Commercial mold inspections tailored to business needs
Detection of mold presence using industry-leading tools
Identification of mold source to prevent recurrence
Free, in-person consultations scheduled within 48 hours
Contact us now to secure your mold inspection appointment.